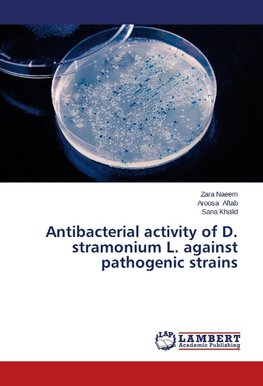
Antibacterial activity of D. stramonium L. against pathogenic strains

-
 Anglický jazyk
Anglický jazyk
Antibacterial activity of D. stramonium L. against pathogenic strains
Autor: Zara Naeem
The present study was undertaken to evaluate the antibacterial activity of a locally found and ethnobotanically important plant Datura stramonium Linn. The crude extract of powdered plant material were obtained in various polar and non-polar solvents viz:... Viac o knihe
Na objednávku
39.05 €
bežná cena: 41.10 €
O knihe
The present study was undertaken to evaluate the antibacterial activity of a locally found and ethnobotanically important plant Datura stramonium Linn. The crude extract of powdered plant material were obtained in various polar and non-polar solvents viz: petroleum ether, chloroform, methanol and distilled water. Well defined zones of inhibition were recorded indicating that Datura stramonium was potent against pathogenic microbes i.e Staphylococcus aureus, Bacillus subtilis and Pasturella multocida. The methanol extract of whole plant showed significant inhibitory zone against Staphylococcus aureus . Hence methanol extract of whole plant was more active against the microbes tested. All the remaining extracts also showed the inhibitory values at some extent. Standard antimicrobial discs were also used to compare the results viz: Ampicillin A, Ampicillin B and Chloramphenicol and they showed significant inhibitory values.
- Vydavateľstvo: LAP LAMBERT Academic Publishing
- Rok vydania: 2014
- Formát: Paperback
- Rozmer: 220 x 150 mm
- Jazyk: Anglický jazyk
- ISBN: 9783659417962












